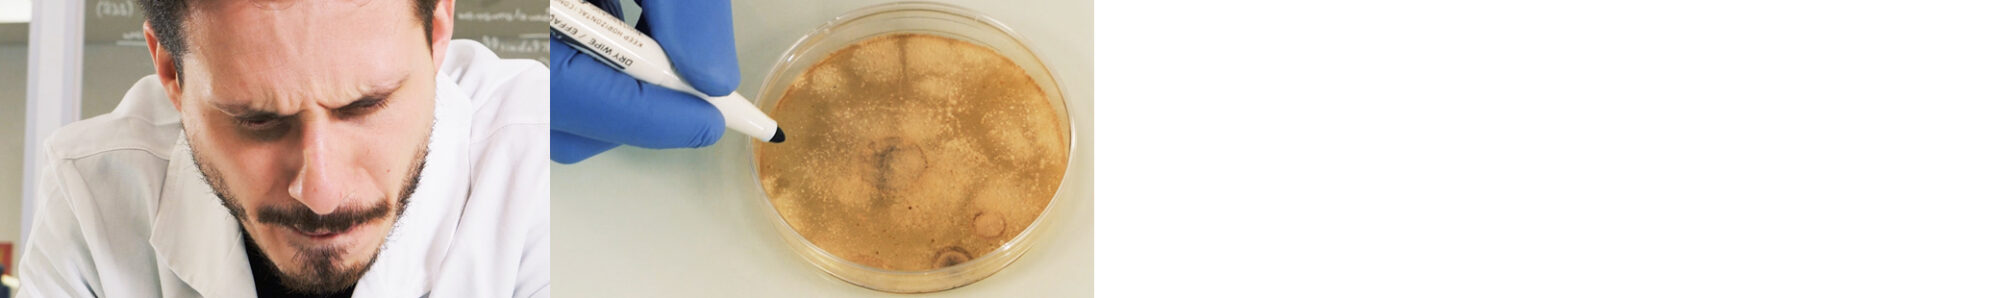

Nowadays, microbiology labs are using several methods for inoculation on a Petri dish. We have the « Spread Plate Method » and the « Plate Pouring Method ».
The « Spread Plate Method » consists in dropping your sample on culture media. With this method you can easily isolate the colonies and simplify their retrieval, for identification for instance. However, the size of the sample must be between 0.1 and 0.5 ml maximum. Beyond that, counting can become very difficult…
However, with the « Plate Pouring Method », you have the possibility to submit a higher sample volume into the Petri dish.
Advantages of the « Plate Pouring Method »
◉ This allows you to be more sensitive on low contaminated samples, on which we are going to look for low pollution.
◉ This is also the best way for all your bacteria developing in a microaerophilic environment.
« Plate Pouring Method » steps :
◉ STEP 1 : Submit your 1 mL sample in an empty and sterile Petri dish.
◉ STEP 2 : Add a first layer of culture media, generally around 10 to 20 ml. Be careful : the media temperature must be under control. If this one is too high, your micro-organisms will not survive !
◉ STEP 3 : The stirring : the movements must be performed following the shape of an “8” in order to spread in the most homogeneous way the sample into the agar.
◉ STEP 4 : Add a second layer of media in order to make sure that no micro-organisms are found on the surface. Obviously, this concerns only the double-layer protocols.
As you may have seen on the video, this method can be done with the help of an automatic system (The DISTRIWEL combined with the MEDIAWEL). This allows you to standardize :
➱ The temperature of the distributed media
➱ The volume
➱ The « 8 » shape stirring

Optimized agitation
With the DISTRIWEL “agitation” option, you can now easily automate your pre-seeded Petri dishes. The device handles the entire process: automatic pouring of the medium onto your samples and optimized agitation in a figure-eight pattern in accordance with current standards.
Double layer: the device can deliver a second layer, ideal for coliform, enterobacterial, and anaerobic bacterial applications.
Why using a Petri Dish Filler by Alliance Bio Expertise :
The DISTRIWEL is an automatic Petri dish filling and stacking machine that allows you to prepare up to 440 plates within 30 minutes.
The DISTRIWEL has a Plexiglas protective cover and a built-in UV lamp to help preventing contamination during the pouring process. It is also important to note that the compact base, the detachable carousel, and the removable transfer plate make the device extremely easy to handle and to clean.

Standalone device
With the DISTRIWEL 440, you can produce culture media of consistent quality in large quantities. The carousel, which is compatible with most Petri dishes, can automatically dispense up to 880 agar plates in just one hour.
👉 Want to learn more about the MEDIAWEL or test it in your lab? Contact us now:
Please complete the form below to contact us:
"*" indicates required fields